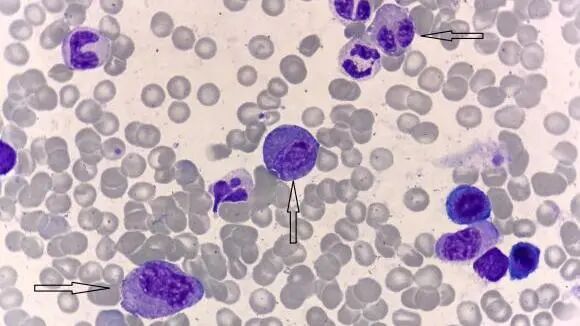
图片

单位 | 山东中医药大学附属医院检验科
慢性髓细胞性白血病(Chronic myeloid leukemia,CML)是骨髓造血干细胞克隆性增殖形成的恶性肿瘤,占成人白血病的15%,国内CML中位发病年龄为45-50岁,较西方更为年轻化[1]。
大多数CML患者以外周血白细胞、幼稚粒细胞、嗜酸、嗜碱性粒细胞比例升高为其典型特征,因此在
患者女,37岁,主诉:发现血小板增多5天。
现病史:患者于5天前查体发现血小板增多,特入住我院,症见:精神可,无头晕
既往史:既往身体健康状况可,否认
体格检查:全身皮肤及粘膜无黄染,未见皮下出血,浅表淋巴结未及肿大。心律齐整,各瓣膜听诊区未闻及杂音,未闻及心包摩擦音。
辅助检查:
1.血常规:WBC 6.57×109/L,RBC 4.84×1012/L,HGB 139g/L,在正常范围。嗜碱性粒细胞(0.68×109/L)、比值(10.4%)、PLT(1550×109/L)均明显增高。
2.骨髓形态:血小板成簇、成片分布,侏儒巨核(黑色箭头)易见(图1)。
骨髓报告:增生明显活跃,1.髓系原始细胞占2%,嗜酸性、嗜碱性粒细胞比值增高,2.血小板增多,形态考虑MPN(ET待排)。


图1 骨髓中巨核细胞 瑞氏-姬姆萨染色(10*100)
3.骨髓病理:
结论:形态学考虑
4.免疫分型:送检骨髓样本原始细胞比例不高,嗜酸性粒细胞及嗜碱性粒细胞占比升高,各系免疫细胞表型未见明显异常。
5.BCR::ABL1融合基因(CML)实时定量PCR检测报告:BCR::ABL1融合基因P210型阳性(+); BCR::ABL1(拷贝数): 256100; ABL1(拷贝数): 243800; BCR::ABL1/ABL1 : 105.045%。
6.染色体:查到Ph染色体易位,见图2。

图2 染色体报告
7.MPN常见31种基因突变:阴性。
结合MICM,诊断为CML。给予
患者男,45岁,主诉:发现血小板增多3月余。
现病史:患者2025年9月份因查体发现血小板增多,血小板计数:427×109/L,于当地医院住院,未予以治疗。入住我院,症见:神志清,精神可,无
既往史:既往身体健康状况可,否认高血压史、否认心脏病、否认糖尿病等慢性疾病病史。乙肝病史20年余、否认结核等传染病史。预防接种史不详。否认输血史。否认药物过敏史、否认其他接触物过敏史。
体格检查:患者全身皮肤及粘膜无黄染,未见皮下出血,浅表淋巴结未及肿大。双肺呼吸音清晰,未闻及干、湿罗音,未闻及胸膜摩擦音。心律齐整,各瓣膜听诊区未闻及杂音,未闻及心包摩擦音。腹部柔软,无压痛、反跳痛,双下肢无
辅助检查:
1.血常规:WBC:9.04×109/L,在正常范围,嗜碱性粒细胞(0.39×109/L)增高,比值(4.3%)增高,RBC(6.07×1012/L)增高,PLT(642×109/L)明显增高。
2.腹部超声:肝实质回声稍粗,其他未见异常。
3.骨髓形态:嗜酸性粒细胞比值偏高,占6%(黑色箭头),可见侏儒状巨核细胞(红色箭头)及畸形血小板(绿色箭头),见图3。

图3 骨髓形态(黑色箭头:嗜酸性粒细胞;红色箭头:巨核细胞;绿色箭头:畸形血小板)瑞氏-姬姆萨染色(10*100)
骨髓报告:骨髓增生明显活跃,形态考虑MPN,结合临床及基因等排除CML。
4.骨髓病理:形态学考虑MPN,粒系比例增大、嗜酸性粒细胞易见伴巨核细胞形态异常,CML待排。
5.免疫分型:送检骨髓样本原始细胞比例不高,
7.BCR::ABL1融合基因:检测出BCR-ABL210基因阳性。
7.染色体:查到Ph染色体,即9号染色体长臂(9q34)上的ABL原癌基因易位至22号染色体长臂(22q11)的断裂点簇集区(BCR),见图4。

图4 染色体报告
8.髓系血液疾病248种基因突变分析:阴性。
结合患者病史及相关辅助检查,明确诊断为CML。给予甲磺酸氪马替尼片口服,患者病情好转后出院。
CML是由 t(9;22)(q34;q11) 易位产生BCR::ABL1融合基因,编码具有显著酪氨酸激酶活性的蛋白质致髓系异常增殖的肿瘤性疾病。常见症状包括疲劳、脾肿大引起的腹部不适等,检测到Ph染色体和(或)BCR::ABL1融合基因阳性方可诊断CML。5%-10% CML患者存在变异Ph染色体,1%-5%患者表现为隐匿性BCR::ABL1重排[常规
本次报道两例CML-T案例均有以下共同特点:
1.二者均为中年人,案例1女性37岁;案例2男性45岁。
2.外周血白细胞总数正常,无幼稚粒细胞,嗜碱性粒细胞比值偏高,血小板增高。案例1嗜碱性粒细胞占10.4%,PLT 1550x109/L;案例2嗜碱性粒细胞占4.6%,PLT 642x109/L。
3.腹部超声,未见
4.骨髓增生明显活跃,中、晚幼粒细胞比例正常,巨核细胞>500个,侏儒巨核细胞易见。案例1原始细胞占2%,嗜酸性粒细胞(6%)、嗜碱性粒细胞(4%)比值偏高,侏儒巨核细胞较案例2更易见、更明显;案例2未见到原始细胞,但嗜酸性粒细胞占6%。
5.Ph染色体阳性,BCR::ABL1融合基因P210阳性,无其他MPN基因突变。
案例1外周血白细胞总数正常,未见中、晚幼粒细胞,仅见嗜碱性粒细胞增多,血小板>1000x109/L,另外骨髓巨核细胞数量>1000个,使我们陷入原发性血小板增多症(ET)这个误区。
ET是起源于造血干细胞异常克隆性疾病,是骨髓增殖性肿瘤(MPN) 的一个亚型。主要表现为外周血中血小板持续性增多,≥450x109/L,伴有出血,反复血栓形成,肝脾轻至中度肿大,病程隐潜,最终进展为骨髓纤维化或向白血病转化[5-6]。
从基因角度分析,ET存在JAK2、CALR 或MPL基因突变,而Ph染色体和BCR::ABL1融合基因阴性,这是ET与CML诊断的根本性区别[7]。从骨髓形态角度分析,ET患者多以体积大、深分叶的“鹿角状”巨核细胞为主[8-10]。二者鉴别见表1。
回顾案例1的骨髓形态,其巨核细胞则呈现出体积小、不分叶或少分叶的“侏儒巨”典型形态特征。鉴于此,在不久后出现的第二例相似患者的骨髓报告中,我们明确给出了CML待排这一结论。
表1 ET与CML-T鉴别点

经典型CML患者中粒系集落形成前体细胞数量增加、细胞增殖能力及成熟能力增强,骨髓中幼粒细胞溢出,导致外周血中 WBC 计数、各阶段幼粒细胞及嗜碱性粒细胞比例明显升高,WBC甚至高达100x109/L以上。
与经典型CML相比,CML-T外周血仅表现为血小板增高,伴嗜碱性粒细胞增高,且脾脏不肿大。因此,对这种发病率低,既往报道少,且临床起病多不典型的CML病例,需要MICM(形态学、免疫学、细胞遗传学、分子生物学)对其综合诊断,而形态学作为MICM的第一要素,起到初筛、定向的作用,指导着临床后续诊疗的开展,形态学工作者需要经历经验积累的漫长之路,任重而道远。
保定市第一医院检验科副主任,临床检验副主任医师,承德医学院内科学副教授
参考文献
(上下滑动查看更多)
声明:本平台旨在为医疗卫生专业人士传递更多医学信息。本平台发布的内容,不能以任何方式取代专业的医疗指导,也不应被视为诊疗建议。如该等信息被用于了解医学信息以外的目的,本平台不承担相关责任。本平台对发布的内容,并不代表同意其描述和观点。若涉及版权问题,烦请权利人与我们联系,我们将尽快处理。
(本网站所有内容,凡注明来源为“医脉通”,版权均归医脉通所有,未经授权,任何媒体、网站或个人不得转载,否则将追究法律责任,授权转载时须注明“来源:医脉通”。本网注明来源为其他媒体的内容为转载,转载仅作观点分享,版权归原作者所有,如有侵犯版权,请及时联系我们。)